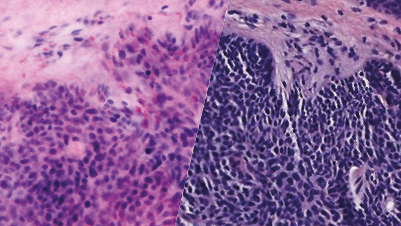

Press Releases
Latest press releases
News
RCM at Evidence level 1b: Highest level possible
Febuary 2, 2025 – Reflectance Confocal Microscopy (RCM) has gained increasing importance in dermatological diagnostics in recent years. This non-invasive method enables a detailed real-time visualization of the skin layers and thus provides a precise assessment of skin lesions. RCM has proven to be particularly useful for improving diagnostic accuracy in lesions that are difficult to classify clinically or dermatoscopically.
In the latest European guidelines for skin cancer diagnostics, RCM has now been officially classified as level 1b evidence. This means that the method is based on the highest level of evidence, which underlines the importance and reliability of this technology. According to the guidelines, reflectance confocal microscopy should be used in particular for the further assessment of skin lesions that appear uncertain during visual inspection or dermatoscopy, provided that the technique is available.
News
Double the number of patients at half the cost: digital innovation in Mohs surgery
The worldwide increase in cancer, predicted by the International Agency for Research on Cancer (IARC), requires the urgent optimisation and digitalisation of current treatment processes. A pioneering study led by Prof. Dr Jan Gutermuth at the University Hospital of Brussels presents a revolutionary approach: the integration of Ex Vivo Confocal Microscopy (EVCM) during Mohs Micrographic Surgery (MMS) for Basal Cell Carcinoma (BCC) using the VivaScope 2500, which has been proven to enable a more precise and faster assessment of tumour extension and resection margins, leading to a significant increase in efficiency. Prof Dr Jan Gutermuth and his team have proven that the waiting time for patients has been reduced, costs have been more than halved and the quality of patient care has been improved. The results have far-reaching implications for the healthcare system by enabling more effective and cost-efficient treatment of skin cancer.
News
New hope for people suffering from pancreatic cancer
Revolutionary study results thanks to the VivaScope 2500 laser scanning microscope.
News
Fluorescence Confocal Microscopy on Liver Specimens for Full Digitization of Transplant Pathology
September 2023 – Rapid evaluation of donor liver specimens for transplantation using the VivaScope® 2500 Technology
News
Economic value of the VivaScope 1500 In Vivo microscope
Extensive large-scale clinical trial demonstrated the therapeutic & economic value of the VivaScope 1500 In Vivo microscope in early diagnosis of Melanoma lesions.
News
Priv.-Doz. Dr. Daniela Hartmann wins the “German Medical Award”
Great success also for VivaScope, the specialist for confocal laser scanning microscopy, because the VivaScope 2500 was part of it.
See Publications:
News
Potential Use of Vivascope for Real-Time Histological Evaluation in Endoscopic Laryngeal Surgery
In this publication, the authors report the suitability of Ex Vivo confocal microscopy, the VivaScope® 2500M-G4, for real-time evaluation of histological samples and micro-fragments of solid laryngeal lesions.
It is well known that incisional biopsies (single or multiple) do not have an accuracy comparable to a definitive histologic diagnosis because the biopsies cannot represent the entire lesion. Moreover, this kind of biopsy can later cause undue damage and fibrosis of the multilayer structure of the vocal cord.
In this study, the innovative VivaScope® 2500 technology allowed rapid examination of 8 histological samples from 8 patients of laryngeal lesions. The resulting VivaScope® images were evaluated and compared to their corresponding paraffin H&E images. The VivaScope workflow to obtain subcellular resolution images of the specimens, took less than 5 minutes. From these images the pathologists were able to evaluate the adequacy of the samples, dysplasia grade, the presence of inflammatory outbreaks, and the surgical margin statuses. The processing of the sample did not alter the specimen for subsequent ancillary analysis. The final histopathological evaluation of the laryngeal samples showed a high level of agreement on diagnosis between the Vivascope evaluation and the definitive histological examination in assessing the presence or absence of carcinoma and/or dysplasia (k= 0.95).
The VivaScope® technology offers the possibility of quickly analyzing the unfixed fresh tissue, leading to considerable saving of time. Therefore, this can enable a “real-time” histological diagnosis of the laryngeal lesion and its margins, allowing the surgeon to extend the resection, if necessary, during the same day procedure. This innovative approach could avoid revision surgeries and the general anesthesia associated risks, and also the sacrifice of healthy tissue.
The novel workflow offers the following advantages:
• Easy and fast sample preparation and image acquisition (within 5 min), without assistance of a well-trained technician
• No laboratory required
• Establish the adequacy of the sample and avoiding loss of healthy tissue
• Diagnosis of the dysplasia grade as well as inflammatory outbreaks
• Safe surgical resection margins on the same day of the procedure
• Remote pathological evaluation with 24/7 availability, in real time
The VivaScope technology could also offer the possibility of conducting a “remote diagnosis” by sharing digital images for counseling with pathologists remotely and also provide the opportunity to build a library of digital images. This digital sharing can also be used to obtain a quick pathological consultation in a hospital where a pathology unit is unavailable, thus allowing for adequate evaluation through remote analysis.
Relevant links
Link: L. De Benedetto, et al. Journal of Personalized Medicine 2023
News
Milestone at Vienna General Hospital: VivaScope revolutionises cancer diagnosis and treatment in Austria
In Austria, around 42,000 people are diagnosed with cancer every year. Although this is a matter of health and therefore the greatest human good, the analogue frozen section – a technique first used in 1895 – is still considered the gold standard for intraoperative pathological assessment when removing tumour tissue. With its “Ex Vivo” technology, the company VivaScope is bringing about a fundamental medical revolution. Thanks to digital optical sections, tumour tissue can be removed more efficiently than ever before and assessed within five minutes using telemedicine. The VivaScope 2500 is now being used for the first time in the field of dermatology at Vienna General Hospital.
News
Priv.-Doz. Dr. Daniela Hartmann wins the “German Medical Award”
Great success also for VivaScope, the specialist for confocal laser scanning microscopy, because the VivaScope 2500 was part of it.